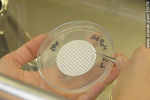
Foto #35170

Fotos de Fray Bentos
URUGUAY > Departamento de Río Negro
X
Significado de los íconos
Inicio |
Condiciones de Uso | Servicios profesionales |
Banco de Fotos | Nuestro Propósito | Contacto |
Comentarios |
Política de Privacidad |
Privacy Policy |
2021 - 25 Años
©Copyright - Stonek Fotografía 1996-2024